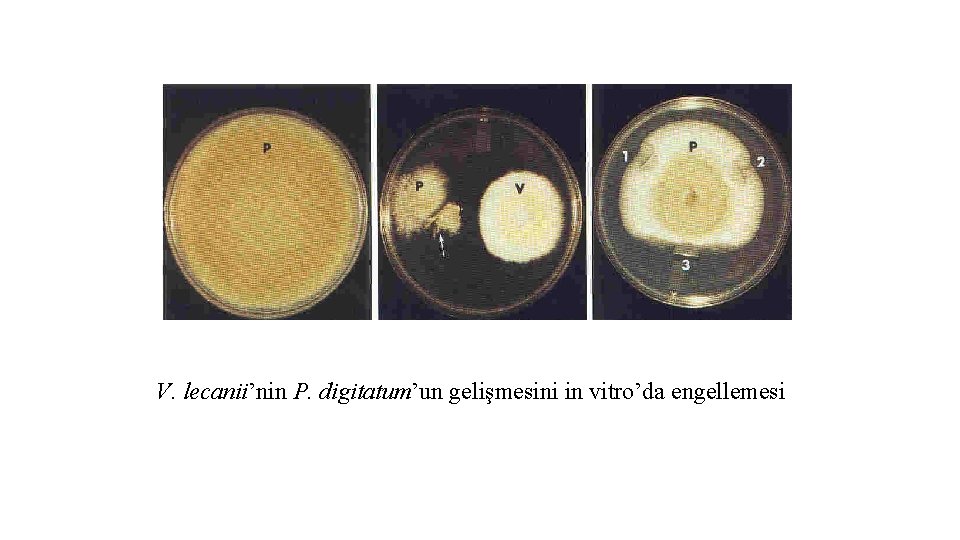
V. lecanii’nin P. digitatum’un gelişmesini in vitro’da engellemesi

3 3 BYOLOJK KONTROL Biyolojik kontrol doal veya

3. 3 BİYOLOJİK KONTROL Ø Biyolojik kontrol, doğal veya modifiye edilmiş mikroorganizmalar veya onların ürettikleri metabolitler kullanılarak, istenmeyen zararlı organizmaların etkisini azaltmak, faydalı böcek veya mikroorganizmaların etkinliğini arttırmak ya da bunu teşvik etmek için bitkilerin cazip hale getirilmesidir.

Ø Bitkilerin sağlıklı yetiştirilmesi için hastalığı baskılayan mikroorganizmaların kullanılmasını da kapsayan biyolojik kontrol ile ilgili çalışmalar 1920 -1940 yıllarında başlamış ve hızla gelişerek, günümüzde bir çok ülkede kültür bitkilerindeki hastalık ve zararlılara karşı etkili olan mikroorganizmalar veya bunların ürünleri ticari olarak üretilmiş ve biyopreperat olarak kullanıma hazır hale getirilmiştir.

Ø Patojene karşı daha fazla spesifik etkiye sahip olması ve bir bütün olarak çevreye etkisinin çok daha sınırlı olması zirai mücadelede kullanılma potansiyelini arttırmaktadır.

Ø Bitki hastalıkları ile mücadelede, biyolojik savaşın başarıyla uygulanabilmesi için biyokontrol organizmalar ile çevresindeki mikrobiyal topluluk arasındaki etkileşimlerin bilinmesi gerekir. Ø Bu etkileşimlerin temelinde ise antibiosis, rekabet, hiperparazitizm ve teşvik edilmiş dayanıklılık (SAR) olmak üzere 4 biyolojik savaş mekanizması yer almaktadır.

Ø Bazı bitki patojenlerini parazitleyip öldüren veya yapılarını bozan etmenlere hiperparazit, çıkardıkları salgılarla, diğer patojenlerin gelişmesini engelleyenlere ise antogonistik organizma denir.

3. 3. 1 Antibiosis Ø Bir organizmanın, başka bir organizmanın metabolitleriyle engellenmesi ya da yıkıma uğratılmasıdır. Ø Bu metabolitler antibiyotikler adıyla bilinir. Ø Genellikle düşük molekül ağırlıklı, uçucu olan ya da olmayan ve ortamda yayılabilen toksik maddelerdir.

Ø Toprakta bulunan pek çok fungus, bakteri ve actinomycet'ler antibiyotik oluştururlar. Ø Funguslardan en çok antibiosis gösteren Trichoderma viride'dir. Bu fungus direkt parazitizm yanında, bir çok fungusta anormal çimlenmeye neden olan Gliotoxin ve ayrıca Viridin toksinlerini oluşturur. Ø Penicillium patulum ve bazı Penicillium türleri Patulin, Penicillin, Griseofulvin antibiyotiklerini oluştururlar.

T. virens stainleri tarafından fazla üretilen glioviridin antibiyotiği pamuk fidelerinde Pythium ultimum’ a karşı kontrol sağlarken, T. virens’ in glioviridin üretmeyen yabani tipi bu patojene karşı başarısız olmuştur (Şekil 4). Ayrıca T. virens’in ürettiği gliotoksinin R. solani’ nin gelişimi üzerinde etkili olduğu tespit edilmiştir (Şekil 5). Şekil 4. T. virens’ in ürettiği glioviridin P. ultimum’ un gelişmesini engellemektedir. A- ana strain, B- glioviridin eksik mutant (Howell, 2003) Şekil 5. T. virens’ in ürettiği gliotoksin R. solani’ nin gelişimini engellemektedir. A- gliotoksin var, B- gliotoksin yok (Howell, 2003). 8

Ø Bacillus subtilis’ in Fusarium roseum ve Rhizoctonia’ ya karşı etkili antibiyotik oluşturan ırkları bulunmaktadır. Ø Virülent Agrobacterium tumefaciens streynleri ile Agrobacterium radiobacter strain K 84 (agrocin-84) arasındaki ilişki, antibiosise dayalı biyolojik savaşın en iyi tanımlanmış örneklerinden birisidir.

Ø Strain K-84 'Un ticari preparatlan, bir çok ülkede sert çekirdekli meyve ağaçları ve güllerin de bulunduğu çok çeşitli bitkilerde kök uru hastalığının biyolojik savaşında kullanılmaktadır. Ø A. radiobacter strain K 84‘ün ticari preparatlarından (NO-GALL, GALLTROL-A vb. ) hazırlanan süspansiyonlara daldırılarak, A. tumefaciens ile bulaşık toprağa dikildiğinde kök urundan etkili şekilde korunabilmektedir. Agrocin-84'ün etkisi tedavi edici değil, patojeni engelleyici niteliktedir.

Ø Buğdayda zor olum (take-all) hastalığının (Gaeumannomyces graminis var. tritici) engellenmesi için tohumlara Pseudomonas fluorescens uygulaması yapıldığında (108, 109 cfu/tohum) hastalığın engellendiği görülmüştür. Ø Burada, Pseudomonas fluorescens’ in strain 2 -79’u demiri bağlayan siderefor üretmesi ve buna bağlı olarak fungusta demir açıklığı ortaya çıkararak onun gelişmesini engeller. Ancak, asıl mekanizma, bir phenazine-carboxylic asit (PCA) yapısında bir antibiyotik ile ilgili olan doğrudan antibiyosistir.

Ø Fluoresent Pseudomonaslar, toprak kaynaklı patojenlerin neden olduğu bir çok hastalığı engeller ve antibiyotik nitelikli çeşitli metabolitler üretirler. Ø Pseudomonas fluorescens’in strain HV 37 a, pamukta Pythium ultimum’un neden olduğu çökerteni engellemektedir. Ø HV 37 a’ nın Pythium ultimum’un gelişimini engelleyen phenazine-1 - carboxylic acid (PCA), hidrojen cyanide (HCN) ve 2, 4 - diacetylphloroglucinol (Phl) gibi 3 çeşit antibiyotik oluşturduğu belirlenmiştir.

Ø P. fluorescens’in strain CHAO’nun hıyar ve tatlı mısır gibi bitkilerde P. ultimum’un neden olduğu çökerten hastalığını pyoluteorin (Plt) ve 2, 4 -diacetylphloroglucinol gibi iki antibiyotik metabolit üreterek engellediği belirlenmiştir. Ø Pamukta P. ultimum’un sebep olduğu çökerteni engelleyen birkaç fungal biyolojik savaş etmenlerinden birisi de Gliocladium virens’dir. G. virens, üretmiş olduğu gliovirin adlı diketopiperazine antibiyotiği ile P. ultimum’un protoplazmasında koagulasyona neden olmaktadır.

Ø Tahıl yapraklarına Bacillus pumilus uygulandığında, Puccinia recondita’nın ürediosporun çim tüplerini üreterek enfeksiyonunu önlemektedir. Ø Puccinia allii (soğan pası)’ye karşı soğan yapraklarına Bacillus cereus uygulandığında pas püstüllerinin sayısında önemli oranda azalma olmuştur.

Ø Bacillus subtilis, B. cereus subsp. mycoides ve B. thuringiensis gibi bakteriler fasülye pası etmeni Uromyces phaseoli’nin ürediospor çimlenmesini engellemiştir. Ø Pseudomonas cepacia’nın Drechslera maydis’e ve yer fıstığında Cercospora yaprak lekesine karşı engelleyici olduğu belirlenmiştir.

Ø Meyve ve orman ağaçlarında kök kanseri hastalığına neden olan A. tumefaciens’e karşı topraktan izole edilen A. radiobacter’in bakterisin adlı antibiyotik üreten 80 nolu ırkı kil-Cerasan uygulamasındaki ilaç yerine kullanılarak başarılı sonuç alınmıştır.

3. 3. 2 Hiperparazitizm Ø Hiperparazitizm, primer bir parazitin üzerinde sekonder bir parazitin etkisi olup, bu mekanizma genellikle fungal patojenlerin neden olduğu hastalıkların baskı, altına alınmasında önemli bir rol oynamaktadır. Ø Parazit bir fungus üzerinde parazit olan diğer bir fungus için ise mikoparazit terimi kullanılmaktadır.

Ø Hücre duvarını eriten veya parçalayan enzimlerin (proteaz, β-1, 3 glukonaz, chitinaz) üretilmesi hiperparazitizmin esasına oluşturarak ya direkt patojen organizmanın ölümüne neden olmakta ya da biyokontrol organizmaya rekabette bir üstünlük kazandırarak patojenin baskı, altına alınmasına yardımcı olmaktadır. Ø Hiperparazitizm, konukçu ve parazitin kesinlikle yakın bir ilişki kurmasını gerektirmektedir.

Ø Bir çok mikroorganizmanın, bitki patojenlerinin gelişmelerini engelledikleri ve bunlardan dolayı oluşacak bitki hastalıklarını önledikleri laboratuvar, sera ve tarla denemelerinde belirlenmiştir. Ø Bugüne kadar sadece 6 mikroorganizma tescil edilmiş ve dünyanın değişik ülkelerinde ticari olarak satılmaktadır. Ø Bu 6 mikroorganizmadan üçünü funguslar oluşturmaktadır.

Ø Bunlar; Gliocladium virens fide yastığındaki bitkilerin fide hastalıklarına neden olan Pythium ve Rhizoctonia'ya karşı Glio. Gard adı ile, Ø Trichoderma harzianum, Botrytis cinerea ve toprak kökenli funguslardan Fusarium graminearum, Guignardia bidwelli, Pythium ultimum, Rhizoctonia solani ve Sclerotinia homeocarpa’a karşı FStop adı ile, Ø Trichoderma harzianum, Trichoderma polysporum ağaç göçüren hastalığının kontrolü için Binab. T adları ile satılmaktadır.

Ø Diğer üç mikroorganizma ise bakterilerden ibaret olup, bunlar; Agrobacterium radiobacter K-84, Agrobacterium tumefaciense karşı Galex veya Galltrol, Ø Pseudomonas fluorescens pamukta fide çökertene neden olan Rhizoctonia ve Pythium’a Karşı Dagger G ve Ø Bacillus subtilis Kodiak ticari adla satılmakta ve çeşitli bitki tohumlarına uygulanmaktadır.

Ø Pas fruktifikasyonlarının bakteriler tarafından parazitlendiği tespit edilmiştir. Ø Pseudomonas fluorescens ve Bacillus megatorium'un Puccinia graminis’in ürediosporunun engellemektedir. çimlenmesini tamamen

Ø Trichoderma’nın Sclerotium rolfsii ve Rhizoctonia solani hifleriyle etkileşime girdiği sırada onların hücre duvarını enzimatik olarak yıkama uğrattığı saptanmıştır. Ø Bezelyede solgunluğa neden olan Fusarium oxysporium fsp. pisi, fasulyede S. rolfsii'ye karşı Serratia marcescens’in kütinolitik enzim üretiminden kaynaklanan hiperparazitizm mekanizmasıyla kontrolleri sağlanmıştır.

Başlıca 4 önemli aşamada gerçekleşir: 1. Mikoparazitin kemotrofik gelişmesi 2. Mikoparazitin konukçuyu tanıması 3. Enzimlerin salgılanması 4. Konukçunun eritilmesi 24

Bu mekanizmayı bir örnek ile açıklayacak olursak; T. harzianum’ un R. solani patojenine yönelerek gelişme gösterir. Bu özellik Trichoderma’ nın konukçusunun hifindeki bazı uyarıcılara ya da konukçu tarafından salgılanan kimyasallara doğru kemotrofik gelişmesidir. Şekil 6. T. harzianum’ un R. solani’ ye doğru kemotrofik gelişmesi 25

Tanımada ise, R. solani hifinde bulunan bir lektin Trichoderma hücre duvarı üzerindeki galactose kalıntılarına bağlanmakta ve agglutinin, konukçunun parazit tarafından tanınmasına neden olmaktadır. Şekil 7. T. harzianum’ un R. solani’ yi tanıması ve sarılması 26

Tanınma ve bağlanmadan sonra, mikoparazit konukçu hifinin etrafında kanca oluşturup, sarılarak gelişir. Bu sırada mikoparazit tarafından konukçuyu tahrip eden enzimler salgılanır. Trichoderma spp. tarafından mikolitik enzimlerin (ekstrasellüler -1 -3 -gluconase, chitinase vb. ) salgılanmasıyla, R. solani’ nin hücre duvarını enzimatik olarak yıkıma uğratır (Harman, 2004). Şekil 8. Trichoderma spp. ’ nin R. solani’ y e sarılması, kanca oluşturması ve penetrasyonu (Harman, 2004). 27

R. solani içerisine giren T. harzianum hifleri hücrenin sitoplazmasını boşalttığı ve hücre duvarında yer çöküntülere neden olduğu tespit edilmiştir. Şekil 9. T. harzianum’ un R. solani hücre duvarındaki çöküntüleri 28

Trichoderma spp. tarafından salgılanan enzimler: Chitinasas § 1, 4 -β-acetylglucosaminidase (Glc. N Acases) § Endokitinaz § Ekzokitinaz T. harzianum, T. atroviride, T. asperellum ENZİMLER § β-1, 3 -glukinaz Glucanases § β-1, 6 -glukinaz T. harzianum, T. atroviride, T. virens Proteases T. harzianum 29

Ø Bakteri hücrelerini eriten, onları parçalayan ve faj adı verilen viruslerin de bitkilerdeki bakteriyel hastalıkların önlenmesinde yararlı olabilecekleri düşünülmüştür. Ø Yapılan çalışmalar sonucunda, birçok fitopatojen bakterilerin (Xanthomonas, Pseudomonas, Agrobacterium, Corynebacterium) fajları saptanmıştır. Fajları kullanarak bitki patojeni bakterilerin enfeksiyonunu önlemek amacını, taşıyan çalışmaların bir kısmında olumlu sonuçlar elde edilmiştir. Ø Fakat, Okabe ve arkadaşları, bu işlemlerin bakteriyel hastalıkları kesin bir şekilde önleyemediklerini ve yalnızca hastalık belirtilerinin ortaya çıkışını engelleyebildiklerini belirtmektedirler.

Ø Fajların patojen olan bakterinin virülensinin değişmesine yol açan toksinlere ait genleri taşıyabilmesi (bu durum, yeni patojenlerin ortaya çıkışında önemli rol oynayabilmektedir), etkinliklerinin ortam koşullarından çok fazla etkilenmesi, bitki dokusu içinde çok az ve sınırlı bir alanda yayılabilmeleri gibi nedenlerden dolayı bakteriyel hastalıkların kontrolünde fajlar önerilmemektedir. Ø Predatör bakteri olarak bilinen Bdellovihrio hacteriovons'un soya fasulyesinde Pseudomonas glycinea‘nın neden olduğu bakteriyel yanıklığın biyolojik savaşımına etkisi üzerine olumlu sonuçlar alınmıştır.

Ø Yerfıstığında zararlı olan Sclerotium rolfsii’ye karşı toprağa Trichoderma viride verilmesinin çok iyi kontrol sağladığı belirtilmektedir. Ø Macaristan ve Avustralya'da bir çok bitkide beyaz çürüklüğüne neden olan Sclerotinia sclerotiorum, ve bazı Sclerotium türlerine karşı melas artıklarında yetiştirilen hiperparazit fungus Coniothyrium minitans toprağa inokule edilmiş ve başarılı bir kontrol elde edilmiştir.

Ø Bazı hastalıklara karşı tohumların antagonistik fungusla bulaştırıldıktan sonra ekilmesi ile iyi sonuç alındığı bildirilmektedir. Ø ABD'de mısırlarda kök yanıklığına sebep olan Fusarium roseum'a karşı Bacillus subtilis ve Chaelomium globosum tohuma bulaştırıldığında hastalık önlenmiştir.

Ø Ülkemizde, antagonistik funguslarla in vitro da yapılan araştırmalar sonucunda ümitvar sonuçlar alınmıştır. Ø Bunlardan önemlileri Sclerotinia sclerotiorum'a karşı Trichoderma spp. , Aspergillus spp. , Penicillium spp. , Bacillus spp. , Pseudomonas spp. ve Actinomycetes türleri; Ø Rhizoctonia solani'ye karşı Trichocderma harzianum; Ø Rhizoctonia solani'ye karşı Peniciliinm patulum antagonistik etki göstermektedir.

Ø Topraktaki abiotik şartların değiştirilmesi ile o ortamdaki mikroorganizma populasyonunun değişmesi kaçınılmazdır. Bu uygulamada, organik gübreler özellikle yeşil gübre ve kuru ürün artıklarının etkileri araştırılmış ve olumlu sonuçlar alınmıştır. Ø Toptakta antagonistik mikroorganizmaları teşvik edecek bazı maddelerin toprağa verilmesi buradaki hiperparazitlerin de artmasını teşvik ederek, topraktaki fitopatojenik fungusların ve buna paralel olarak oluşturdukları hastalıkların azalmanı sağlamaktadır.

Ø Patates uyuzuna neden olan Streptomyces scabies yeşil gübre uygulaması ile pamuk solgunluk hastalığı etmeni Verticillium dahliae kuru yonca parçalarının toprağa karıştırılması ile baskı altına alınabilmektedir. Ø Bu metot, saprofit eğilimi fazla olan patojenlere karşı başarılı olamamaktadır. Ayrıca her türlü toprak koşullarında da olumlu sonuç vermemektedir.

Ø Ayrıca toprağın kısmi sterilizasyonu ve toprağa selektif fungisit uygulanması ile benzer sonuçlar alınabilmektedir. Ø Bu tip uygulamalar toprakta bitki patojenlerine antagonist olan veya toksik antibiyotikler oluşturan Trichoderma veya çeşitli Actinomycetes’ler gibi mikroorganizmaların aktivitelerini ve çoğalmalarını teşvik etmektedir.

Ø Örneğin, karbon sülfür (CS 2)'le fumige edilmiş toprakta diğer organizmalar öldüğü halde, Armillaria mellea ve diğer bir çok patojeni öldüren antagonistik Trichoderma viride canlı kalmaktadır. T. viride, bilhassa Thiram uygulanan toprakta teşvik edilmekte ve Pythium ultimum'un sebep olduğu kök çürüklüğü hastalığı biyolojik olarak engellenmektedir. Ø Sıcaklık uygulaması da topraktaki mikroflorayı, değiştirmektedir. Oldukça düşük derecelerinde yapılan sıcaklık uygulaması, antagonistik mikroorganizmaların gelişmelerini kamçılamaktadır.

Pas, mildiyö ve küllleme etmenleri ile Pythium, Helminthosporium ve Sclerotium'a hiperparazit olan bir çok fungus bilinmektedir. Bunlar;

• Sclerot Oluşturan Fungus Mikoparazitleri • Sclerot Oluşturan Funguslar • Coniothyrium minitans • S. sclerotiorum, Sclerotium cepivorum, Botrytis cinerea, Claviceps purpurea • Sporidesmium sclerotivorum • S. cepivorum, S. minor, • B. cinerea , S. sclerotiorum • Talaromyces flavus • S. sclerotiorum • Gliocladium virens • S. sclerotiorum • G. catenulatum • S. sclerotiorum • Laetisaria arvalis • Rhizoctonia solani

Bitkilerde önemli hastalıklardan biri olan küllemelere karşı, - Ampelomyces quisqualis ve Tilletiopsis spp. ’leri etkili mikoparazitlerdir. A. quisqualis’in biyopreparatı elde edilmiş ve sebze, elma ve bağda görülen küllemelere karşı kullanılmaktadır. Özellikle de, Erysiphe cichoracearum ve Sphaerotheca fluginea’ya karşı başarılı bir türdür. T. minor, T. pallescens ve T. washingtionensis türleri de, değişik külleme etmenlerinin konidi ve hif gelişimini azaltarak etkili olmaktadır.

Şekil 3. 8. Küllemenin chasmothecium yapısını parazitleyen Ampelomyces quisqualis Şekil 3. 9. Küllemenin konidiofor yapısını parazitleyen Ampelomyces quisqualis 42

S. f T. p S. f Tilletiopsis pallescens’in S. fuliginea’ya etkisi T. p

Bitki patojenlerine Karşı Kullanılan Diğer Mikoparazit Funguslar • V. lecanii • Uromyces spp. , S. fluginea, • Penicillium digitatum • Pythium oligandrum • Verticillium dahliae • P. nunn • Phytophthora spp. • Hansfordia pulvinata • Cladosporium fulvum • Pichia guilliermondii • B. cinerea • Fusarium proliferatum • Plasmopara viticola
V. lecanii’nin P. digitatum’un gelişmesini in vitro’da engellemesi

P. nunn hiflerinin, Phytophthora spp. hifleri etrafında tutunarak gelişmesi ve parazitlemesi

a b a- Fusarium proliferatum’un hifleriyle Plasmopara viticola’nın sporangium ve sporangiophore’larının kaplanması b- F. proliferatum hiflerinin P. viticola hiflerini çevirmesi

Virüsler daha çok bakteriyel etmenler üzerinde hastalık yapmakta ve onları öldürmektedirler. Bakterileri öldüren böyle virüslere bakteriyofaj denir. Örneğin Elma ve Armutla Ateş Yanıklığı (Erwinia amylovora) ve Bakteriyel Solgunluk (Ralstonia solanacearum) hastalıklarına karşı etkili bakteriyofajlar bulunmuştur. Bakteriler Bazı bakteriler diğer bakteriyel ve fungal bitki hastalıkları ve zararlı yabancı otlarda hastalık yapmaktadırlar. Bunlardan bazıları yaygın olarak kullanılmaya başlanmış olmasalar bile üzerinde birçok çalışma yapıla gelmektedir. Çizelge 1‘de bazı hastalıklara karşı kullanılan önemli bakteriler verilmektedir.

Çizelge 1. Biyolojik savaşta kullanılan bakteriler ve etkiledikleri patojenler Bakteri Kullanıldığı Hastalık Agrobacterium rhizogenes Strain K 84 Agrobacterium tumefaciens Bacillus subtilis Fusarium spp. Bacillus megaterium Phytium spp. Rhizoctonia solani Macrophomina phaseolina Sclerotium spp. Erwinia herbicola Muhtelif bakteriyel etmertlere Pseudomonas fluorescens Pamukta Kök Çürüklüğü Funguslarına Rhizobium spp. Verticillum dahliae

Zararlı Organizma Aktif Madde Ruhsatlı Bku ELMA Elma karalekesi (Venturia inaequalis) % 0, 3 Bacillus subtilis GB 03 ırkı 1, 2 x 10 üzeri 7 cfu/gram COMPANION (İTHAL) Fungisit 500 ml/100 l su - 07. 2017 ARMUT Ateş yanıklığı (Erwinia amylovora) % 0, 3 Bacillus subtilis GB 03 ırkı 1, 2 x 10 üzeri 7 cfu/gram COMPANION (İTHAL) Fungisit 500 ml/100 l su - 07. 2017 PATATES KÖK BOĞAZI NEKROZU VE SİYAH SİĞİL HASTALIĞI ((Rhizoctonia solani)) % 0, 3 Bacillus subtilis GB 03 ırkı 1, 2 x 10 üzeri 7 cfu/gram COMPANION (İTHAL) Fungisit 500 ml/100 kg Tohum - 05. 2017 BAĞ Kurşuni küf (Botrytis cinerea) % 0, 3 Bacillus subtilis GB 03 ırkı 1, 2 x 10 üzeri 7 cfu/gram COMPANION (İTHAL) Fungisit 500 ml/100 l su 06. 05. 2016 BİBER (Sera) Kurşuni küf (Botrytis cinerea) % 0, 3 Bacillus subtilis GB 03 ırkı 1, 2 x 10 üzeri 7 cfu/gram COMPANION (İTHAL) Fungisit 500 ml/100 l su 06. 05. 2016 ÇİLEK (Sera) Kurşuni küf (Botrytis cinerea) % 0, 3 Bacillus subtilis GB 03 ırkı 1, 2 x 10 üzeri 7 cfu/gram COMPANION (İTHAL) Fungisit 400 ml / 100 l su Domates (Fidelik) FİDE KÖK ÇÜRÜKLÜĞÜ (Fusarium oxysporum, Rhizoctonia solani) % 0, 3 Bacillus subtilis GB 03 ırkı 1, 2 x 10 üzeri 7 cfu/gram COMPANION (İTHAL) Fungisit 500 ml / da % 0, 3 Bacillus subtilis Sebzelerde beyaz çürüklük (Sclerotinia GB 03 ırkı 1, 2 x 10 üzeri sclerotiorum) 7 cfu/gram COMPANION (İTHAL) Fungisit 400 ml / da ÇÖKERTEN HASTALIĞI % 0, 3 Bacillus subtilis (Rhizoctonia solani, Fusarium spp. , GB 03 ırkı 1, 2 x 10 COMPANION (İTHAL) Fungisit Pythium spp. , Alternaria spp. , üzeri 7 cfu/gram Sclerotinia spp) 1000 ml / da HIYAR (Sera) TÜTÜN (Fide dönemi) Grubu Dozu Son İlaçlama ile Hasat Arası Tavsiye Tarihi Süre Bitki Adı

% 1, 5 1 x 108 kob / ml min Pseudomonas fluorescens strain Bitki Adı Zararlı Organizma Ruhsatlı Bku Grubu Dozu Son İlaçlama ile Hasat Arası Süre Tavsiye Tarihi PATATES KÖK BOĞAZI ÇÜRÜKLÜĞÜ VE SİYAH SİĞİL HASTALIĞI (Rhizoctonia solani) CEDRİKS (İTHAL) Fungisit 500 ml/100 kg tohum - 05. 2017 ÇİLEK (tarlasera) Kurşuni küf (Botrytis cinerea) CEDRİKS (İTHAL) Fungisit 300 ml/100 L su - 10. 03. 2017 HIYAR (Sera) ÇÖKERTEN (Fusarium spp. , Pythium spp. , Rhizoctonia spp. ) CEDRİKS (İTHAL) Fungisit 300 ml/da BAĞ Kurşuni küf (Botrytis cinerea) CEDRİKS (İTHAL) Fungisit 300 ml / 100 l su 03. 04. 2015

Funguslar Biyolojik savaşta kullanılan funguslar genelde fungal hastalıklara karşı etkilidirler. Ayrıca yabancı otlara karşı etkili olan fungal hastalıklar vardır. Bu funguslar tohuma, toprağa veya bitki üzerine püskürtme şeklinde uygulanmaktadırlar. Bazı etkili örnekleri olmasına rağmen çok yaygınlık kazanmamışlardır. Biyolojik savaşta kullanılan bazı örnekler Çizelge 5' de verilmiştir.

Çizelge 5. Biyolojik savaşta kullanılan bazı funguslar ve etkiledikleri hastalık etmenleri Ampelomyces quisqualis Serada küllemelere karşı Aspergillus spp. Phytophthora ve Fusarium spp. Chaetomium globosum Kök çürüklükleri Coniothyrium minitans Sclerotinia sclerotiorum Penicillium spp. Rastık ve kök çürüklükleri Peniophora gigentae Fomes annosus Sporidesmium sclerotivorum Sclerotinia minor Trichoderma hamatum Trichoderma harzianum Trichoderma koningii Trichoderma viride Kök çürüklükleri hastalıkları başta olmak üzere birçok hastalığa karşı

Bitki Adı Zararlı Organizma Aktif Madde Ruhsatlı Bku Grubu BAĞ Bağ küllemesi (Erysiphe necator) % 58, 5 x 10 üzeri 9 cfu / ml Ampelomyces AQ 10 (İTHAL) Fungisit quisqualis isolate M 10 DOMAT ES (Sera) Patlıcangillerde külleme (Leveillula taurica) % 58, 5 x 10 üzeri 9 cfu / ml Ampelomyces AQ 10 (İTHAL) Fungisit quisqualis isolate M 10 Dozu 5 g / 100 l su Son İlaçlama Tavsiye ile Hasat Tarihi Arası Süre 18. 06. 2010

Bitki Adı HIYAR (Sera) Zararlı Organizma TOPRAK KÖKENLİ PATOJENLER (Rhizoctonia solani, Fusarium solani) Aktif Madde % 1, 15 Trichoderma harzianum rifai ırk KRLAG 2 1, 10 x 10 üzeri 7 cfu/g minimum spor Ruhsatlı Bku ROOTSHIELD GRANULES (İTHAL) Grubu Dozu Fungisit 650 g / m 3 Son İlaçlama Tavsiye ile Hasat Tarihi Arası Süre 07. 10. 200 9

Bitki Adı Zararlı Organizma Aktif Madde Ruhsatlı Bku Grubu Dozu KÖK ÇÜRÜKLÜĞÜ (Fusarium 10 üzeri 8 cfu/g + Trichoderma oxysporum, aspellerum ırk ICC 012 ve REMEDİER® ÇİLEK Macrophomina Trichoderma gamsii ırk ICC (İTHAL) phaseolina, Phythium 080 spp. , Rhizoctonia solani) Fungisit 300 g / da FİDE KÖKÇÜRÜKLÜĞÜ 10 üzeri 8 cfu/g + Trichoderma BİBER (Rhizoctonia solani, aspellerum ırk ICC 012 ve REMEDİER® (Sera) Trichoderma gamsii ırk ICC (İTHAL) Fusarium oxysporum, 080 Fusarium spp. ) Fungisit 250 g / da DOMAT ES (Sera) FİDE KÖK ÇÜRÜKLÜĞÜ (Pythium spp. , Rhizoctonia sp. , Alternaria spp. , Fusarium spp. ) 10 üzeri 8 cfu/g + Trichoderma aspellerum ırk ICC 012 ve REMEDİER® Trichoderma gamsii ırk ICC (İTHAL) 080 Fungisit 250 g / da Son İlaçlama ile Hasat Arası Süre

3. 3. 3 Hipovirulens Ø Bir virülens azalışı olarak bilinen bu olay, virülent bir patojen ve onunla akraba olan daha az virülent bireyler arasındaki hibridizasyon ve hiperparazitizmin bir sonucudur. Ø İlk kez kestane kanseri etmeni fungus ile ilişkili bir özellik olarak ortaya çıkan hipovirülens, bazı bitki hastalıklarının biyolojik savaşımında potansiyel öneme sahip bulunmaktadır.

Ø Cryphonectria (Endothia) parasitica (kestane kanseri etmeni)’nin pigmentsiz (beyaz) strainlerinin, Ø normal pigmentli (turuncu) virulent starinlerinden daha az virulent olduğu, Ø bu özelliğin C. parasitica’nın bir straininden diğerine Ø hifsel anastomosis (fuzyon) yoluyla sitoplazmik olarak aktarılabileceği belirlenmiştir.

Ø Belirlenen bu hipovirulent strainin hifleri bir Avrupa kestane ağacındaki kanserli dokunun kenarına bırakıldığında, burada yara dokusu oluşarak enfeksiyon yeri şişmiştir. Ø Sonunda kanser kapanarak anormal kanser görünümünü almıştır. Ø Fransız ve italyan hipovirulent strainlerinin Amerika'da bulunan virulent pigrnentli C. parasitica strainlerine sitoplazmik olarak aktarılabileceği, bu durumun kanseri kapatma yeteneğine sahip olduğu belirlenmiştir

Hipovirülensin Kullanıldığı Patojenler Hipovirülens, ds. RNA bulunduran stoplazmik ve birbiriyle uyuşan strainler arasında hifsel anastomosis yoluyla; & Cryphonectria parasitica & G. graminis var. tritici & Diaporthe ambiqua & Ceratocystis ulmi & R. solani (hipovirülense ds. RNA yerine p. RS 64 isimli bir plasmid neden olmaktadır).


3. 3. 4 Rekabet Ø Biyolojik kontrol mekanizmalarından rekabet, mikroorganizmalar arasındaki karışık etkileşimlerin bir sonucudur. Ø Aynı yerde yaşayan mikrobiyal populasyonlar arasında "mikrobiyal interferans" adı verilen sürekli bir etkileşim vardır ve bir ortamdaki mikrobiyal populasyonlar arasındaki ilişkiler çok karmaşıktır. Ø Bu etkileşim, karmaşık işlemler sonucu kendini bir populasyonun aleyhine ve diğer bir popülasyonun Iehine olarak gösterir.

Ø Belli bir habitat içinde organik ve inorganik besin maddeleri, yer, ışık ve su biyolojik gereksinimi karşılayamayacak duruma düştüğünde, mikroorganizmaların bu faktörler için yaptıkları mücadeleye rekabet denir. Ø Rekabet bir türün bireyleri arasında ise intraspesifik rekabet, iki türün bireyleri arasında ise interspesilik rekabet olarak tanımlanır.

Ø İntraspesifik rekabet durumunda bireylerin tüm çevresel istekleri aynı olduğundan, ortamda hangi faktör azalmış ve büyümeyi sınırlayıcı duruma girmişse, o faktör için rekabet başlar.

Ø Diğer taraftan interspesifik rekabette türlerin çevresel istekleri farklı olduğundan, genellikle ortamda azalan ve sınırlayıcı olan bir faktör her iki tür için de aynı derecede sınırlayıcı olmadığından, doğada daha ziyade intraspesifik rekabete rastlanmaktadır. Ø Mikroorganizmaların generasyon süresi kısa ve populasyon yoğunlukları yüksek olduğundan, aralarındaki rekabet, diğer canlılar arasındaki rekabete göre çok daha yüksektir. Kolonize olan mikroorganizmalar en iyi şekilde rekabeti kazanmış ve yerlerine adapte olmuş organizmalardır.

Ø Mikroorganizmaların rekabette başarılı olmalarında hangi özelliklerinin etkili olduğu tam olarak aydınlatılamamış fakat, büyüme hızı, pigment ve ekstra polisakkarit üretebilmeleri, spor oluşturmaları, büyüme faktörlerine olan ihtiyaç gibi özelliklerin bu konuda etkin olduğu belirtilmektedir. Ø Besinler için rekabet konusundaki en çarpıcı ve başarılı biyokontrol çalışmaları demir için yapılan rekabet üzerinedir. Demir, genelde toprakta bol olmasına rağmen, suda çözünmeyen bir formda bulunmaktadır. Aeroblar ve fakültatif anaeroblar metabolik fonksiyonlar için demire gereksinim duyarlar.

Ø Demirin kısıtlı olduğu ortamlarda ise mikroorganizmalar demir iyonlarına yüksek afinitesi olan, düşük moleküler ağırlıklı sideroforları üretmektedirler. Ø Sideroforlar, Pseudomonas’lar (P. fluorescens, P. putida) tarafından üretilen ve hastalıkların baskılanmasında rol oynayan fluorescent pigmentlerdir. Ø Bu pigmentlerin, toprağın p. H'sının yüksek olması durumunda, patojenin kullanabilecegi Fe 3’ün miktarını şiddetle azaltan biostatik bileşikler olarak fonksiyon gösterdiği varsayılmaktadır.

Ø Sideroforların demiri fungus ve bakteriler için kullanamaz hale getirmesi nedeniyle, demir noksanlığı oluşturarak, toprak kaynaklı patojenlerin gelişimini engellediği kabul edilmektedir. Ø Patateslerde tohumluk yumru çürümesine neden olan Erwinia carotovora subsp. atroseptica (Eca)’nın engellenmesinde fluoresent Pseudomonasların siderofor üretiminin rolü olduğu saptanmıştır. Ø Pseudomonas putida tarafından üretilen sideroforların Fusarium klamidosporların çimlenmesini ya da mikrokonidilerin çim borucuğunun uzamasını önlediği belirlenmiştir.

Ø Laboratuar ve sera testleri bazı rizosfer bakterilerinin tohum, yumru ya da toprağa uygulandığında bitki gelişimini arttırdığını göstermiştir. Ø Bitki gelişimini uyaran bu rhizobakterilerin (PGPR) çoğu, demirin kısıtlı olduğu besi yerinde geliştirildiğinde sarımsı-yeşil fluoresent pigmentler olan sideroforları üreten Pseudomonas spp. 'dir. Ø Hollanda'da sürekli patates yetiştirilen tarlalarda NPK eksikliği ya da bitki hastalıklarına bağlı olmaksızın yumru veriminde giderek bir azalma gözlenmiştir.

Ø Bu ürün azalışının zararlı rizosfer mikroorganizmalarının çeşitli metabolitler üreterek bitki gelişimini etkilemesinden kaynaklandığı öne sürdürülmüştür. Ø Yumrulara uygulanan Pseudomonas putida ve P. fluorescens'in salgıladığı sideroforların hidrojen siyanid üretimini engelleyerek topraklardaki verim azalışını önlediği belirlenmiştir.

Ø Biyolojik kontrolde nonpatojen (patojen olmayan) organizmaların rekabet yeteneğinden yararlanılmaktadır. Ø Yumuşak çekirdekli meyve ağaçlarında ateş yanıklığı hastalığının biyolojik savaşımında Erwinia fluorescens’in Erwinia herbicola ve Pseudomonas amylovora’nın çiçek enfeksiyonlarını engelleme yeteneklerinin antibiyotik üretiminden çok, yer veya besin için rekabetten kaynaklandığını belirlenmiştir.

Ø Elis ve ark. , kök urunun biyolojik kontrolünde Agrobacterium radiobacter’in K-84 straininin, agrocin-84 üretmesinin gerekli ancak, yeterli olmadığını, yara yerlerindeki rekabetin de etkili olduğunu saptamışlardır.

Ø Biyolojik kontrolün etkisi, biyokontrol organizmalarının fitopatojen bakteriyle başarılı bir şekilde uzun dönem rekabete girebilmesine, doğal şartlar altında gelişebilmesine ve hayatta kalabilme özelliğine bağlıdır. Ø Bu sebeple, biyolojik kontrol üzerindeki çalışmalar, özellikle rizosfer ve phyllospher'deki yaygın bakteriler üzerinde yoğunlaşmıştır. Bu bakterilerin uygun kullanımları sonucu elde edilen bilgiler Tablo 2'de verilmiştir.

Tablo 2. Rizosfer ve Phyllosher’deki Patojenlerin Gelişimini Engelleyen Biyokontrol Organizmalar( Sigee, 1993).

3. 3. 5 Uyarılmış Dayanıklılık Ø Bitkilere de insanlardaki gibi bağışıklık kazandırılabileceği fikri ilk kez, 1913 yılında ileri sürülmüş ancak, bu konu son 30 yılda kapsamlı olarak ele alınmıştır. Ø Bugün bazı ürünlere bağışıklık kazandırılabileceği belirlenmiş ve bağışıklığın mekanizması bir çok yönleriyle çözülmüştür.

Ø Patojenlere karşı bitkilerin savunma mekanizmaları aktif ve pasif olarak sınıflandırılmaktadır. Ø Bir patojenin bitki dokusu içerisine penetrasyonu kütikula, hücre duvarı veya koruyucu kimyasallar gibi pasif on koruyucu mekanizmalarla önlenmektedir.

Ø Eğer bir patojen bu savunma mekanizmalarına rağmen bitkiye penetrasyonu başarırsa, çeşitli spesifik reaksiyonlan içeren aktif bir savunma cevabıyla karşılaşır. Ø Savunma mekanizmalarının çoğu patojen saldırısıyla başlar ve bitkiyi sadece enfeksiyonun olduğu tarafta lokal olarak değil, aynı zamanda bitkinin her tarafını koruyan bileşik bir tepki şeklinde sonuçlanmaktadır.

Ø Sistemik dayanıklılık, zirai mücadele açısından en önemli mekanizma olup, biyolojik kontrol organizmalarının bitki ile olan etkileşimi sonucu, bitkilerin sistemik dayanıklılık mekanizmalarının aktif hale getirilmesi esasına dayanmaktadır. Ø SAR ile ilgili ilk çalışma A. Frank Ross tarafından 1961'de yayılanmıştır. Lokal lezyon konukçularında TMV’yi kullanan Ross, TMV enfeksiyonlarının önceki bir enfeksiyonla sınırlandığını tespit etmiştir.

Ø Ayrıca, bu direncin yalnızca TMV'ne karşı değil tütün nekroz virüsü, funguslardan Phytophthora nicotianae, bakterilerden Pseudomonas tabaci ve hatta bazı afitlere karşı da etkili olduğu bulunmuştur.

Ø Tersine, tütünde kök lezyonuna neden olan Chalara elegans (Thielaviopsis basicola) fungusu veya yaprak lezyonuna neden olan Pseudomonas syringae bakterisi inokule edildiğinde de TMV'ye karşı teşvik edilmiş sistemik dayanıklılık gelişmiştir. Ø Son 30 yılda SAR dayanıklılık çalışmaları, hem virus ve bakterileri hem de agronomik olarak önemli olan birçok fitopatojenik fungusları içine alacak biçimde genişletilmiştir.

Ø Bitkilerde dayanıklık sistemi çeşitli mekanizmaları içermektedir. Bu mekanizmalardan birisi; düşük moleküler ağırlıklı antimikrobiyal maddeleri (fitoaleksinler), hemen enfeksiyon yerinde ve çevresinde birikmesidir. Ø Hastalıklara dayanıklılığa yol açan diğer bileşikler arasında β-1, 3 gluconase, chitinase gibi fungal ve bakteriyel hücre duvarlarına zarar veren litik enzimlerin sentezi, patogenesisle ilgili proteinlerin sentezi (Pathogenesis related= PR), fiziksel bariyerler, lignifikasyon, suberin, kallus ve agglutinin oluşumu sayılabilir.

Ø Bitkilerde hastalığa dayanıklılık sistemini uyaran diğer mekanizmalar ise normal bir patojenin avirulant ırkryla, nonpatojen organizmayla, antibiyotilk etkisi olmayan sentetik immunornodulatörlerle ve yetiştirme ortamı olarak kompost kullanımıyla teşvik edilebilmektedir.

Ø Normal bir patojenin avirulent ırkıyla kurulan SAR'ın temelinde hipersensitif reaksiyon (HR) yatmaktadır. Ø Biotik uyarıcıların inokule edilmesiyle yapraklarda başlatılan dayanıklılığa, lokalize olmuş kazanılmış dayanıklılıkk (LAR) adı verilmekte ve bu kısımda enfeksiyon noktasındaki konukçu hücrelerin hızlı bir şekilde ölümüyle sonuçlanan lokal lezyonlar meydana gelmektedir.

Ø Oluşan lokal reaksiyonlar, antimikrobiyal aktiviteyi sağlayan ve fitoaleksinler olarak bilinen maddelerin senteziyle desteklenmektedir. Ø Konukçu bitkilerin bir patojenin farklı fizyolojik ırklarına karşı dayanıklılığı veya duyarlılığı, konukçu ve patojendeki uygun gen çiftleriyle belirlenmekte ve bu şekildeki gen için gen etkileşimlerinde birçok bitki dayanıklılık genleri (R), patojen avirulenslik (avr) gen ürünlerini tanıması ile başlamaktadır. Ø Bu ise hipersensitif tepkinin karakterize ettiği genetik uyuşmazlığa yol açarak teşvik edilmiş savunmayı oluşturmaktadır.

Ø HR mekanizması kullanılarak bitkilerin patojen enfeksiyonlarını kontrol etmesi sadece avirulent patojen dayanıklı konukçu ilişkisinde görülmez. Ø Aynı zamanda konukçu ile patojenin HR 'la sonuçlanan uyumsuz etkileşimi avirulent strain duyarlı konukçu bitki, virülent bakteri/dayanıklı konukçu bitki ve virulent bakteri konukçu olmayan bitki ilişkisini içermektedir. Ø Bu konuda Arabidopsis-P. syringae patosistemi üzerinde yoğun bir şekilde çalışılmaktadır.

Ø Bir çalışmada, hıyar, kavun ve karpuz bitkilerinin virüs, bakteri ve funguslar ile sınırlı enfeksiyonu sonucunda virüs, bakteri ve fungusların neden olduğu hastalıklara karşı sistemik olarak dayanıklılık oluşturulabileceği belirlenmiştir. Ø Fasulyeler Colletotrichum lindemuthianum’un neden olduğu antraknoza, tütünler Peronospora tabacina’nın neden olduğu mavi küfe (mildiyö), Burkholderia solanacearum'un neden olduğu bakteriyel solgunluk ve TMV'ne karşı sistemik olarak dayanıklılık kazandırıldığı bulunmuştur.

Ø Nekroz oluşturucu patojenlerin yanı sıra patojenik olmayan mikroorganizmalar, özellikle bitki gelişimini uyaran kök bakterilerinin strainleri de sistemik dayanıklılığı uyarmaktadır. Ø Liu ve ark. , PGPR ( P. putida strain 89 B-27 ve Serratia marcescens 90 -166) kökenli uyarılmış dayanıklılığın hıyarda antroknozun yanı sıra CMV (Cucumber Mozaic Virus), bakteriyel köşeli yaprak lekesi (P. s. pv. lachrymans) ve solgunluk etmeni Erwinia tracheiphila gibi birden çok patojene karşı etkili olabileceğini belirlemişlerdir.

Ø Bir başka araştırmada ise yine bir PGPR (Plant growth-promoting rhizobacteria= Bitki gelişimini teşvik eden rizobakteri) straini olan Ø P. fluorescens WCS-417'nin turpta F. oxysporum'a karşı sistemik dayanıklığı uyardığı bulunmuştur. Ø Ancak, patojen kökenli sistemik uyarılmış dayanıklılıkta (SIR) patojenite ilişkili proteinlerin (PR) sentezi ve enfeksiyon yerinde birikmesi yoluyla hastalıkta azalış saptanırken PGPR kökenli SIR'da PR'nin sentezi belirlenmemiştir.

Uyarılmış Dayanıklılığın Bazı Üstünlükleri; Ø Bağışık kılma viral, bakteriyel ve fungal hastalıklara karşı etkilidir. Ø Uyarılmış dayanıklılık, çeşitli mekanizmaların etkisi ile ortaya çıktığından daha stabildir. Ø Tek yanlı metabolik etkili sistemik fungisitler, patojenin yeni ırklar oluşturması karşısında etkisiz kalır. Ø Uyarılmış dayanıklılık sistemiktir, Ø Uyarılmış dayanıklılık kalıcı ve bazen tek yıllık bir bitkinin hayatı boyunca kalıcı olabilir.

Ø Tütün ve kabakgillerde uyarılmış dayanıklılık aşı ile nakledilebilmektedir. Bu durum aşı ile üretilen bitkiler için oldukça önemlidir. Ø Uyarılmış dayanıklılık gösteren bitkilerden eksrakte edilen kimyasal maddelerle bitkilere bağışıklık kazandırılabilmesi, bunun ileride tohum ilaçlaması ya da bitkilere püskürtülmesi ile de kullanılabileceği umudunu doğurmaktadır. Ø Ancak, uyarılmış dayanıklılığın bugünkü teknoloji ile henüz rekabet edecek kadar ekonomik olmaması ve kalıcılık açısından doğada yoğun patojen şartlarında henüz yeterince tarla denemelerine geçilmemesi gibi bazı sorunları da bulunmaktadır

3. 3. 6 Bitki Savunma Aktivatörleri Ø Bitkilerdeki birkaç virüs (TMV gibi), fungus (Peronospora tabacina gibi) ve bakteriye (Pseudomonas syringae gibi) dayanıklılık birkaç sentetik bileşiklerin bitkiye enjeksiyonu ile bitki yapraklarına püskürtülmesiyle veya bu bileşiklerin kök ya da yaprak sap, ile absorbsiyonu ile teşvik edilebilir.

Ø Salisilik asit (2 -hidroksi benzoik asit), 2, 6 -dikloroizonikotinik asit (INA) ve benzothiadiazole (Actigard CGA 245704) gibi dayanıklılık başlatan kimyasallar, SAR gen kodlanışını uygun seviyeye çıkartmaktadır. Ø Tütün TMV model sistemi kullanılarak, tespit edilen ve SAR genleri adı verilen 9 gen familyasının, inokule edildiği bitkilerin enfekte olmamış yapraklarında m. RNA sentezini başlattığı belirlenmiştir. Bu 9 gen familyasından 5’i PR proteinlerini kodlamaktadır.

Ø PR proteinlerinin gerçek fonkiyonunu bilinmemesine rağmen, bunların ya direkt antimikrobiyal aktiviteye ya da antimikrobiyal proteinlerin sentezlenmesinde enzim aktivitesine sahip oldukları düşünülmektedir.

Ø Bu proteinlerin bir kısmı, β-1, 3 glucanases ve chitinases'i şifreleyerek hücre duvarını parçalarken, bir başka SAR gen sınıfı olan thaumatin benzeri proteinler de antifungal etki göstermektedir. Ø PR proteinlerinin koruyucu fonksiyonunun en önemli ispatı PR-1 a tütün geninin ekspresyonunu ile hastalığa dayanıklılık gösteren transgenik tütün bitkileriyle yapılan çalışmalardan elde edilmiştir.

Ø Yapılan bir araştırmada, transgenik bitkilerdeki PR-1 a'nın yüksek seviyede oluşunun, Oomycetes sınıfına ait iki patojenin (Peronospora tabacina ve Phytophthora parasitica) enfeksiyonunu azalttığı saptanmıştır.

Ø Yapılan deney sonuçlarını SAR'ın başlamasında ve gelişiminde salisilik asitin (SA) önemli bir rol oynadığını göstermektedir. SA konsantrasyonu, bir patojenin enfeksiyonundan sonra, dikkate değer bir şekilde yükselmektedir. Ø SA’in SAR'da bir uyarıcı olduğunu gösteren en belirgin delil, Pseudomonas putida'dan bir salisilat monooksigenazi (Nah. G) sentezleyen transgenik tütün bitkileriyle yapılan çalışmalardan sağlanmıştır.

Ø Bu enzim SA'in catechol'a dönüşümünğ katalize etmektedir. Nah. G sentezleyen bitkiler, patojen enfeksiyonuna tepki olarak SA biriktirmez ve viral, bakteriyel veya fungal patojenlere karşı SAR başlatamaz. Ø White ve ark. (1979) yaptıkları bir araştırmada eksogen SA'in, tütünün TMV'ne karşı dayanıklılığını kuvvetlendirdiğini göstermişler ve benzer şekilde SA'in hıyar kotiledonlarına uygulanmasının Colletotrichum lagenarium bulmuşlardır. fungusuna karşı oluşan dayanıklılığı başlattığını

Ø Tütün tohumlarının geliştiği ortarma SA ilavesi ise enterobakter E. c. subsp. caratovora'ya tam bir dayanıklılık oluşmasına yol açmıştır. Ø C. lagenarium veya tütün nekroz virüsü (TNV) ile enfeksiyondan sonra hıyar floeminde endojen SA birikimi gözlenmiştir. Ø TMV'ü ile inokule edilen tütün bitkilerinin enfekte olmuş ve enfekte olmamış kısımlarında da PR-1 proteininin sentezi ile beraber SA seviyesinin en az 50 kat arttığı tespit edilmiştir.

Ø Yapılan çalışmalarda, biyolojik kontrolün phyllospherden ziyade rizosferde daha başarılı olduğu görülmektedir. Ø Çünkü rizosfer, patojenlerin saldırısına karşı bitkinin kökü için adeta koruyucu bir bariyer görevi yapmaktadır. Ø Yapılan çalışmalarda toprak organik maddesinin hem patojenlerin hem de onların gelişimini engelleyen biyokontrol organizmaların inokulum potansiyelini ve dosyalarıyla da hastalık şiddetini etkilediği saptanmıştır.

Ø Bu etkideki en belirgin özelliğin ise organik kalıntılardaki ayrışma seviyesi olduğu belirlenmiştir. Ø Organik maddelerin sınırlı miktarda ayrışması sonucu topraktaki biyokontrol organizmaların besin açlığı çekmesi sonucu etkilerinin azaldığı tespit edilmiştir. Ø Bir çok attığın kompostlanması ve olgunlaşma işlemleri negatif bitki gelişimini önlemek ve hastalıklara dayanıklılığı geliştirmek amacıyla geliştirilmiştir. Ø Bu konuda yapılan çalışmalar daha çok kompostlar üzerinde yoğunlaşmıştır.

Ø Kompostlar humus niteliğinde olup, tarımsal işletmelerde bulunan çöplerin hayvansal artıklarının, sap saman gibi harman atıklarının, mutfak atıklarının, şehir çöplerinin ve organik yapılı bazı fabrikasyon artıklarının çeşitli işlemlerden sonra mikrobiyal ayrışma sonucu mineralize olmalarından elde edilir. Ø Bunlar aerobik ayrışmaya uğradığından patojenlerden arınmış, funda toprağı kokusu ve görünümünde organik yapılı gübrelerdir.

Ø Organik maddece zenginliği, içerdiği mikrobiyal aktivite, su tutma ve havalandırma kapasitesinin iyi olmasıyla kompostun fiziksel strüktürü bitkilerin sağlıklı gelişimine ve hastalıklara olan direncine yardım etmektedir. Ø Ancak organik maddelerin ayrışım seviyesinin derecesi önemli olduğu için biyolojik kontrolün mümkün olduğu ayrışma seviyesine ulaşması için yeterince stabilize edilmesi gerekmektedir

Ø Popilaspora byssina, kültür mantarı (Agaricus bisporus) miselleriyle kompost üzerinde yer için yarışmaya girerek, kültür mantarlarının kompostu kolonize etmesini engellediği, ancak komposta fluoresent Pseudomonaslar inokule edildiğinde, kahverengi alçı hastalığı etmeninin kolonizasyonunun önlendiği belirlenmiştir. Ø Budde ve ark. arpa bitkisinin kompostta yetiştirilmesi durumunda Erysiphe granminis'in gelişimini belirgin bir şekilde azalttığını ve kontrollerle kıyas edildiğinde bitkilerin % 80 oranında hastalıktan korunduğunu tespit etmişlerdir.

1. 3. 3. 7 Çapraz Koruma Ø Çapraz korunma da, uyarılmış dayanıklılık gibi, bitkinin içinde oluşan bir biyolojik savaş mekanizmasıdır. Ø Çapraz koruma, birinci organizma (antagonist) tarafından, konukçu doku içerisinde ikinci organizmanın (virulent patojen) antibiosis, yer ve besin için yarışma, hifsel interferens ya da parazitizm gibi mekanizmalardan biri kombinasyonu ile önlenmesini içermektedir. veya bunların

Ø Uyarılmış dayanıklılığın etkisi dolaylıdır ve birinci organizma tarafından uyarılır uyarılmaz mikroorganizmalara karşı bitkilerin aktif savunma mekanizmalarını harekete geçirmesiyle ilgilidir. Ø Çapraz korumada kullanılan uyarıcı izolat, ya engel olunmak istenen patojenle akrabadır (zayıf virulent bir strain) ya da diğer ürünlerin benzer dokularında patojendir. Ø Bu akraba strainler (yada benzer dokuların patojenleri), aynı ekolojik nişe uyum sağlamış herhangi iki organizma gibi, bir dokudaki tüketilebilir benzer materyaller için yarışa girebilirler.

Ø Bir patojenin ılımlı ya da zayıf virülent strainleri olarak bilinenler bile bitki canlılığı ve verimliliği üzerinde olumsuz bir etkiye sahip olabilir veya bir konukçu üzerinde zayıf patojenik özelliği gösteren bir organizma, aynı agro-ekosistemde yetişen başka bir bitki üzerinde birden bire patojen olabilir. Ø Bir virüsün ılımlı bir straini, yakın akraba strainlere karşı koyucu olsa bile, bazen ilişkili olmayan strainlerle sinergistik olarak etkileşime girerek, bir konukçuda şiddetli simptomlar oluşturabilir.

Ø Bu gibi olumsuzluklar nedeni ile ticari anlamda kullanımları, oldukça sınırlıdır. Ø Ancak, çapraz korumanın başarılı olduğunu gösteren somut önekler de bulunmaktadır.

Ø Çapraz korumanın ticari kullanımıyla ilgili en başarılı örneklerden birisi, Brezilya’da turunçgillerde Citrus Tristeza Virus (CTV)'ünün virulent strainini önlemek için CTV'nin ılımlı bir straini ile turunçgillerin inokulasyonudur. Ø Tristeza'ya tolerant anaç üzerindeki CTV'na karşı korunmuş aşı kalemleri J 968'de üreticilere dağıtılmıştır. Ø 1 O yıl içinde 5 milyon çapraz korunmuş turunçgil ağacı dikilmiş, 1980'e kadar Brezilya'da 30 milyon ağaç korunmuştur.

Ø Sera domateslerinin TMV’ye karşı çapraz korunması Kanada, İngiltere, Hollanda ve Japonya gibi ülkelerde ticari olarak uygulanmaktadır. Ø Avrupa'da bunun kullanımı, M 11 -16 olarak adlandırılan TMV’nin simptom oluşturmayan yapay bir mutantının geliştirilmesiyle giderek yaygınlaşmıştır. Ø Fransa'da 10 milyondan fazla domates bitkisi bu yolla korunmuştur. Ancak, TMV’nin mutant M 11 -16 straininin yeni mutasyonlarla virülent straine dönme olasılığı nedeniyle son yıllarda kullanım kısıtlanmaktadır.

Ø Spesifik avirulent fungusların uygulanmasıyla elde edilen çapraz koruma ile ilgili ticari uygulamalar yoksa da, bu mekanizma aracıyla doğal olarak oluşan bazı biyolojik savaşım önekleri bilinmektedir. Ø Fransa' da, kavun Fusarium solgunluğuna dayanıklı olduğu bilinen Chatearenard bölgesinin toprakları yüksek oranda saprofit F. oxysporum'un oxysporum patojenik populasyonuna olmayan sahiptir. üyelerinin F. belirti oluşturmaksızın, bir çok bitkinin kortikal dokularında (endofit) bulunduğu bilinmektedir.

Ø Bu bulgular, patojenle akraba olmayan non-patojenler tarafından, önceden kolonizasyon yoluyla köklerin korunmasının bu toprakta Fusarium solgunluğunun görülmesini belli ölçüde engellemektedir. Buharla pastorize edilmiş toprağa, patojenik olmayan F. oxysporum ırklarının verilmesi ile dayanıklılık sağlanmaktadır. Ø F. oxysporum'un, bir bitki türünde patojenik, bir forma specialis (f. sp. )'inin bir başka bitki türüne önceden inokulasyonuyla elde edilen F. oxysporum patojenleri arasındaki çapraz koruma konusunda bir çok araştırma vardır.

Ø Bu biyolojik savaş yaklaşımı, sera şartlarında veya fide olarak yetiştirilen bitkilerde uygulanabilir. Ø Fideler non-patojenik ırk ya da forma specialis ile bulaşık toprağa dikilebilir veya fide kökleri tarlaya şaşırtılmadan önce nonpatojenik strainin spor süspansiyonuna daldırılarak inokule edilebilir. Ø F. oxysporum f. sp. dianthi kullanılarak, domateste F. oxysporum f. sp. lycopersici’ ye karşı oluşturulan çapraz korunmada, ajanın inokulum yoğunluğunun patojeninkine yakın ya da daha yüksek olması gerekmektedir.

Ø Biyokontrol ajanı, patojenden birkaç gün önce uygulandığında koruma etkili olmakta ve bu etki 3 -4 hafta içinde sona ermektedir. Ø Wymore ve Baker, korumanın geçici olduğunu, avirulent F. oxysporum ırkı, ile inokulasyonun domateste Fusarium solgunluğunu gerçek belirtmektedirler. anlamda önleyemeyeceğini

Ø Çapraz korumanın gücü, inokulasyon için patojen olmayan ırkın doğru seçilmesine bağlıdır. Ø Japonya’ da tatlı patatesin gövdesinden izole edilen avirulent bir F. oxysporum straini ile tohumluk yumru parçalarının inokulasyonu yoluyla tatlı patateslerin bütün sezon süresince korunduğu belirlenmiştir.

4. FİZİKSEL YÖNTEMLER Fiziksel yöntemler, başlıca mekanik ve termik yolları içermektedir. 4. 1 MEKANİK YÖNTEMLER Ø Bunlar, hastalık etmenini uzaklaştırmak ya da oluşumunu engellemek amacıyla yapılan uygulamalardır. Ø Sonbaharda meyve bahçelerinde yere dökülen hastalıklı yaprak ve meyvelerin, ağaçta kalan meyvelerin, kurumuş dal ve sürgünlerin, tümörlerin temizlenmesi, bazen iyileşme ümidi olamayan ve hastalık kaynağı olabilecek bitkilerin kökünden çıkarılıp yok edilmesi, sık yapılan ve yapılması gereken işlemlerdir.

Ø Mekanik yöntemlerin uygulanması esnasında dikkat edilmesi gereken bazı hususlar bulunmaktadır. Ø Bunlardan birincisi, hastalıklı bitki kısımlarının patojenin spor üretiminden önce uzaklaştırılmasıdır. Ø Ayrıca hastalık kaynağını tam olarak devre dışı bırakmak için hasta kısımlar sağlam dokudan da 15 -20 cm olacak şekilde kesilip yakılmalı ya da derin bir şekilde toprağa gömülmelidir.

Ø Kışı hastalıklı dallarda geçiren zeytin dal kanseri (Pseudomonas savastanoi), sert çekirdekli meyve ağaçlarında monilya (Monilinia Iaxa) ve elma küllemesi (Podosphaera leucotricha) hastalıklarında, mücadelenin temelini hastalıklı dal ve sürgünlerin kesilmesi oluşturmaktadır.

Ø Ancak kesme ve budama işlemleri yapılırken, kullanılan aletlerin % 1'lik sodyum hipoklorit ya da % 2'lik formaldehitle sık dezenfekte edilmesi (özellikle bakteri ve virüsler için daha önemlidir), kalınlığı; 5 cm'den büyük olan budama yaralarının önce % 0, 5 -1 'lik sodyum hipoklorit, %70’lik alkol veya %5’lik bordo bulamacı ile dezenfekte edilmesi, sonra üzerine 10: 2: 2 oranında lanolin+reçine+tutkal ya da cerano+bordo bulamacı+shelac karışımlarından birinin sürülmesi gerekir.

Ø Meyve ağaçlarının dal ve gövdelerinde hastalık etmenleriyle zararlılar için barınak olabilecek yosun, liken ve çatlamış olan kabuklar keskin bir alet veya sert bir fırça ile kazınmalıdır. Bu işlem, bilhassa asma gibi çatlak kabuklu bitkiler için çok daha önemlidir. Ø Tarlalarda, bitki artıklarının sürerek toprak altına devrilmesi de mekanik bir yöntemdir. Ø Ancak, çoğu kez mekanik mücadele termik yolla tamamlanmaktadır. Şöyle ki toplanan hastalıklı bitki materyali imha edilmek üzere yakılmaktadır

4. 2 TERMİK YÖNTEMLER Ø Termik yöntemler, hastalık etmenlerinin yok edilmesi ya da uzaklaştırılması için yapılan sıcaklık uygulamalarını içermektedir. Bu yöntemler, sıcaklıkla toprak sterilizasyonu, solarizasyon, çoğalma organlarının dezenfeksiyonu, bitkileri virüsten arındırma ve depolama öncesi ürünlerin iyileştirilmesi amacıyla yapılmaktadır.

4. 2. 1 Sıcaklıkla Toprak Sterilizasyonu Ø Isıtılarak toprağın dezenfekte edilmesi, seralarda ve fide yastıklarında uygulanmaktadır. Ø Bu işlem, modern seralarda daha çok sıcak buharla, diğer bazılarında ise kuru sıcak hava ile gerçekleştirilir. Ø Bu sterilizasyon, toprağın en az 30 dakika, 82 'C'nin üzerindeki sıcaklıkta tutulması ile gerçekleşir. Ø Bu sıcaklıkta, toprakta bulunan tüm bitki patojenleri imha edilmektedir. Toprak sterilizasyonu, bazen elektrik enerjisi ile sağlanan bir sıcaklık uygulaması ile yapılmaktadır.

4. 2. 2 Solarizasyon ( Güneş Enerjisi İle Toprağın Dezenfeksiyonu) Ø Güneş ışınlarından yararlanılarak toprağın ısıtılması, bu yöntemin temelini oluşturmaktadır. Ø Bu işlem için, önce derin bir toprak işleme yapıldıktan sonra toprağın iletkenliğini arttırmak ve topraktaki patojenler ile bunların dinlenme yapılarının aktivite kazanmaları amacıyla toprak sulanır. Ø Sulama işleminden 1 -2 gün sonra toprak yüzeyi düzeltilir ve bastırılır.

Ø Daha sonra toprak yüzeyi, nem kaybı olmayacak şekilde şeffaf veya siyah polietilen örtü ile tamamen kapatılır. Ø Toprağın nemini korumak için, 10 -14 gün ara ile sulama işlemi tekrarlanır. 4 -6 hafta sonra örtü kaldırılarak ekim veya dikim yapılabilir. Ø Nemli toprağın polietilen örtü ile kapalı tutularak ısıtılmasıyla, toprak kökenli patojenlerin yanı sıra nematod, yabancı ot ve çiçekli parazit bitkilerin de kontrol edildiği vurgulanmaktadır.


4. 2. 3 Bitki Üretim Organlarına Sıcak Su Uygulaması Ø Birçok bakteriyel, fungal ve hatta bazı viral etmenlerle bulaşık tohumlar, sıcaklık uygulaması ile temizlenebilmektedir. Ø Sıcaklık uygulamasının temeli, tohumların canlılıklarına zarar vermeksizin, içindeki veya üzerindeki patojenleri öldürmektir.

Ø Yöntem basit gibi görünmesi ile birlikte, bilgi ve tecrübe isteyen bir tekniktir. Patojeni öldüren sıcaklık derecesi, tohumun enzimatik ve fizyolojik işlevlerine zarar vermemelidir. Ø Tohumun zarar gördüğü sıcaklık derecesi tohumun su içeriğine, dinlenme döneminde olup olmamasına, yaşına ve diğer canlılık fonksiyonlarına bağlıdır. Ø Canlı materyalin su içeriği artıkça, sıcaklığa duyarlılık da o oranda artar. Ø Buna karşın, dinlenme dönemindeki materyaller (tohum, soğan, yumru veya tomurcuk) termoterapi uygulamasına dayanıklıdır.

Ø Tohumların normal sıcaklıktaki suda ıslatılmasının bile (anaerobik şartlar oluşturulması ve ıslatma esnasında oluşan bazı organik asitlere bağlı olarak) hastalık etmenleri üzerinde olumsuz etkisi olduğu belirlenmiştir. Ø Tohumlara termoterapi (sıcaklık) sıcak su, kuru sıcaklık ve sıcak buhar hava karışımları şeklinde uygulanmaktadır. Ø Sıcak su uygulaması, sıcak hava uygulamasından çok daha önce başlamıştır. Ø Sıcak hava uygulamaları sıcak suya oranla daha yüksek sıcaklıklarda ve daha uzun süre tatbik edilebildiğinden, özellikle eliminasyonunda daha etkili sonuç vermektedir. virüslerin

Ø Tohumluğun sıcak su ile temizlenmesi işlemi ilk defa 1883 yılında patates mildiyösü (Phytophthora infestans) hastalığına, daha sonra yulaf ve arpadaki açık rastık hastalıklarına (Ustilago avenae, U. nuda hordei) karşı uygulanmıştır. Ø Sonraları uygulama yaygınlaşmış ve 1921 yılında kereviz yanıklığını (Septoria apiicola), elimine etmek amacıyla, kereviz tohumlan 48 -49 °C'de 30 dakika sıcak su ile muamele edilmiş ve başarılı olmuştur.

Ø ABD ve Avustralya'da sıcak su uygulaması, karnabahar ve lahana tohumlarındaki Xanthomonas campestris bakterisini elimine etmek için tatbik edilmiştir. Ø Bu uygulamada adı geçen bakteriyle birlikte tohumlardaki Alternaria sp. de kontrol edildiği halde Phoma sp. fungusu etkilenmemiştir

Sıcak su uygulamasının dezavantajları 1. Tohumların canlılığını veya çimlenme gücünü kaybetmeleri söz konusudur. Bilhassa bayat ve zayıf tohumlar daha fazla etkilenirler, 2. Bir defada sıcak suya tabi tutulacak tohum miktarı azdır (genellikle 0, 5 -2, 5 kg), 3. Suyun başlangıçtan uygulama sonuna kadar aynı sıcaklık düzeyinde tutulması oldukça güçtür, 4. Her tohum patojeni için etkili değildir. Örneğin; nohut, bezelye veya fasulye gibi büyük tohumların antraknoz gibi hastalıklarına etkisizdir.

Ø Bazı hastalıklarda bu yöntem, sistemik fungisitler piyasaya çıkıncaya kadar tek savaşım yolu olarak yıllarca uygulanmıştır. Örneğin, hububatlarda açık rastıkta tohumun embriyosunda bulunan patojen bu yolla etkisiz hale getirilmektedir. Ø Bu yöntemde dikkat edilecek nokta, sıcaklık ve sürenin çoğalma materyaline zararlı uygulanmasıdır. olmayacak şekilde belirlenmesi ve

Ø Sıcak su uygulaması sebzelerde daha yaygın olarak kullanılmakta ve bir çok tohum kökenli patojen bu yolla elimine edilmektedir. Bu uygulama lahana, karnabahar, şalgam, havuç, turp, ıspanak, marul, domates, biber, patlıcan ve hıyar gibi tohumların bilhassa bakteriyel kökenli patojenler için geniş çapta yapılmaktadır. Ø Burada da sıcak su uygulamasında dikkatli davranılmalı, aksi taktirde bilhassa duyarlı tohumlar (Cucurbitaceae familyası gibi) zarar görebilir.

Sebzelere sıcak su uygulaması, aşağıdaki gibi yapılır; 1. 0, 5 -2, 5 kg tohum gevşek dokulu pamuk bez torbaya yarıya geçmeyecek şekilde konur ve ağzı kapatılır. 2. Torba 38 o. C sıcaklıktaki su banyosunda 10 dakika bir ön ısıtmaya tabi tutulur. 3. Sonra torbalar her sebze için önerilen sıcaklığa tam olarak ayarlanmış su banyosuna daldırılır ve uygun süre bekletilir (Tablo 3).

Tabla 3. Sebze Tohumlarına Sıcak Su Uygulanması İçin Gerekli Olan Uygun Sıcaklı Tohumlar için uygulanan ikinci termoterapik yöntem, kuru sıcaklık uygulaması olup, başarı şansı daha azdır.

4. Uygulama sonunda, torbalar hemen soğuk suya daldırılarak, soğutulur. 5. Soğutulan tohumlar, düzgün bir zemine serilerek kurutulur. 6. Termoterapi uygulanmış tohumlar daha sonra toprak kökenli fungal patojenlere karşı uygun fungisit ile ilaçlanır.

4. 2. 3. 1 Sıcaklık Uygulaması İle Bitkilerden Patojenlerin Elemine Edilmesi Ø Sıcaklık uygulaması, bir çok virüs, fitoplazma ve zorunlu vasküler bakterilerin neden olduğu hastalıklarda başarı ile uygulanmaktadır. Ø Bu yöntemde dormant halde bulunan bitkilere veya yumrulara 3554 o. C sıcaklık dereceleri sınırları içinde birkaç dakika ile bir kaç saat süren sıcak su uygulaması yapılmaktadır.

Ø Virüs hastalıklarına karşı ilk termoterapi uygulaması, patates yaprak kıvırcıklığı virüs (PLRV) hastalığına karşı patates yumrularında yapılmıştır. Dormant durumdaki patates yumruları yüksek sıcaklık derecelerine karşı fazla duyarlı olmadıklarından, bunlara 54 o. C'ye kadar sıcaklık uygulanabilmektedir. Ø Hindistan'da günlük sıcaklığın 42 o. C'ye ulaştığı bölgelerde, 6 aylık yaz döneminde depolanan yumrularda yaprak kıvırcıklığı virüsünün elimine olduğu görülmüştür. Virüslerin termoterapi ile eliminasyonunda, değişken sıcaklıklar sabit olanlardan daha etkilidir.

Ø Aktif olarak gelişen bitkilere de benzer şekilde sıcak su uygulaması, fakat daha çok sıcak hava uygulaması yapılmaktadır. Ø Sıcak hava için genellikle 35 -40 o. C optimal sıcaklık olarak belirlenmiştir. Ø Sıcak hava, sera veya büyütme oda ve kabinleri gibi kapalı yerlerde uygulanmaktadır.

TMV Domates ve Biberde CGMMV Hıyarda MNSV Kavunda P. syringae pv. lachrymans X. campestris pv. vitians F. oxsporum f. sp. lycopersici Verticillium dahliae F. oxysporum f. sp. niveum F. oxysporum f. sp. lagenaria 70°C’de 2 gün 70°C’de 2 -6 gün 70°C’de 3 gün 70°C’de 1 -4 gün Tohumlar önce 40°C’de 24 saat tutulduktan sonra 75°C’de 7 gün sıcak havada tutulmuşlardır.

4. 2. 3. 2 Depolanacak Bitki Materyaline Sıcak Hava Uygulaması Ø Hasattan sonra depolanacak ürünlerin bir süre sıcak havada tutulmaları, bunlar üzerindeki fazla nemin giderilmesini, yaraların kapanmasını sağlayarak, enfeksiyonu önleyebilir. Ø Örneğin, tütün yapraklarına sıcak hava uygulaması, yapraklardaki nemi uçurarak, onları çeşitli saprofit fungal ve bakteriyel etmenlerden korur.

4. 2. 4 Düşük Sıcaklık Uygulaması Ø Düşük sıcaklık, hasat sonrası hastalıklardan korunmada genel olarak kullanılan bir yöntemdir. Ø Genellikle sulu dokulu bitki aksamlarının depolanmasında kullanılmaktadır. Ø Özellikle 0 o. C'nin hemen üzerindeki düşük sıcaklıklar bitki dokuları üzerinde veya içinde bulunan patojenleri öldürür veya en azından onların gelişmesini yavaşlatır ve geciktirir. Ø Böylece yeni enfeksiyonların oluşmasını veya mevcut enfeksiyonların ilerlemesini önler.

Ø Bu yöntem, "hem depolama hem de taşımada uygulanmaktadır. Bu amaçla, depolanacak ürünlerin donmasına, kurumasına ve fizyolojik bozukluğa uğramasına sebep olmayacak en düşük sıcaklık dereceleri uygulanır. Örneğin, patates 5 -8 o. C'de çürümeden, daha uzun bir süre muhafaza edilebilir. Ancak bunun altındaki sıcaklıklarda zarar görür. Ø Penicillium, Monilinia ve Botrytis gibi düşük sıcaklıklarda gelişebilen patojenler de bulunmaktadır.

Depo sıcaklık ve nemleri sebze türlerine göre değişiklik gösterir. Sebze Türü Sıcaklık Nem % Depolama Süresi Karnabahar -1, 0 C 90 4 -8 hafta Yeşil fasülye 3 -4 C 85 1 -2 hafta Erkenci lahana -0, 5, 0 C 85 4 -8 hafta Geçci lahana -0, 5, 0 C 80 -85 30 hafta Havuç -0, 5, 0 C 90 -95 35 hafta Kırmızı lahana -3, -2 C 90 -95 8 -12 hafta Salatalık 0 -1 C 90 2 -4 hafta Ispanak -1, 0 C 90 -95 2 -3 hafta Olgun Domates 0 -1 C 90 -95 4 -6 hafta Genelde depoya konan sebzelerin dış kısımları bulaşık, iç kısımları temizdir. Sebzelerin yüzey kısmında çok fazla çeşit ve sayıda mikroorganizma bulunur. Bunlar rüzgar, toprak, su ve böcekler yardımı ile sebzelere kadar ulaşır. Uygun bir ortamda çeşitli zararlara neden olur.

Meyvelerde her ürün için depo sıcaklığı ve nem miktarı saptanmıştır. Bunlardan bazıları şöyledir; Meyve türü Sıcaklık (0 C) Orantılı nem (%) Depolama süresi Elma 0. 5 -4 85 -95 17 -34 hafta Armut 1 -0. 0 88 -92 6 -30 hafta Muz 12 -15 90 3 hafta Çilek 0. 1 85 -92 5 -10 gün Portakal 4 -5 90 13 -17 hafta Şeftali -1 -0. 0 85 -90 1 -4 hafta Erik -1 -0. 0 90 1 -3 hafta Özellikle meyveler olgun dönemlerinde içlerinde bulunan çok zengin besin maddeleri nedeniyle mikroorganizmaların gelişmesi için çok uygun ortamlar oluşturur. Genelde meyvelere zarar veren hastalık etmenlerini funguslar (mayalar , küfler, parazitik funguslar ) ve bakteriler olarak ikiye ayırabiliriz. Funguslar ya bahçeden depoya enfekteli olarak gelir yada bulaşma depoda gerçekleşir.

4. 3 RADYASYON UYGULAMASI Ø Ultraviole ve X ışınları gibi elektromanyetik radyasyonları veya alfa, beta gibi partikül radyasyonları meyve ve sebzeler üzerinde bulunan patojenleri öldürmek suretiyle, hasat sonrası hastalıkları kontrol etmede kullanmak için çalışmalar yapılmaktadır. Ø Bu konuda bazı başarılı sonuçlar elde edilmiştir. Ancak bazı patojenleri imha etmek amacıyla gereken radyasyon dozları, bitki dokularına zarar vermektedir. Bu gün ticari amaçla bitki hastalıkları radyasyonla kontrol edilmemektedir.

Virüs Hastalıkları İle Mücadele Virüs hastalıkları ile mücadele zordur. Bir kez enfekteli hale gelen bitkinin yeniden eski durumuna dönmesi mümkün değildir. Kimyasal mücadele yöntemleri günümüzde pratikte bitki virüslerine karşı kullanılmamaktadır. Bu sebeple virüs hastalıkları ile mücadele, yayılma ve bulaşmayı önleyici tedbirlere dayanmaktadır. En etkili yöntem dayanıklı çeşit kullanmaktır. Eğer problem olan virüs türüne dayanıklı bitki çeşidi varsa ve bölgeye uygun bir çeşitse mücadelede en ekonomik yol bu çeşidin kullanılmasıdır. Ayrıca, başlangıçta sağlıklı fidan, tohum, çelik, yumru vs. . üretim materyalleri ile üretime başlanmalıdır. Vektörler ile yayılan virüs türlerine karşı vektör populasyonunu düşürücü önlemler alınmalıdır.

Yaprak bitleri, ekonomik önemi olan bir çok virüs hastalığının taşıyıcılığını yapar. Yaprak bitleri ile taşınma farklı olabilmektedir. Sebzelerde hastalık oluşturan bir çok virüs türü (Patates Y virüsü, Hıyar mozayik virüsü, Yonca mozayik virüsü vs. . ) yaprak bitleri tarafından çok kısa bir zamanlık (birkaç sn. ile birkaç dakika) beslenme sonrasında alınır ve yine aynı kısa sürede bulaştırılır. Yaprak biti mücadelesinde kullanılan ilaçlar sistemik (bitki bünyesine giriş yapan) özelliktedir. Bu nedenle ilacın etki etmesi için önce bitki öz suyundan böceğin beslenmesi ve bir sürenin geçmesi gerekir. Oysaki ilaç böceğe etki edene kadar virüs kısa sürede bulaştırılmaktadır. Bu sebeple açık alanlarda (tarla-bahçe) söz konusu virüslerin mücadelesinde günümüzde bazı üreticilerin yaptığı gibi yaprak bitlerine insektisit uygulaması ekonomik olmamakta, aksine boşuna ilaçlama masraflarını yükseltmekte ve çevreyi kirletmektedir. Eğer asıl sorun yaprak biti değil de virüs ise, bu durumda kısa sürede bulaştırılan virüsler için çevreden bulaşma devam ettiği sürece vektöre karşı ilaçlama Yapılmamalıdır. Bunun yerine sarı yapışkan tuzaklar kullanılabilir. Vektöre karşı kimyasal mücadele ancak bulaştırılması için uzun süreye gerek duyan Floem dokusundaki virüsler (örnek patates yaprak kıvırcıklık virüsü) için önerilebilir.

Yabancı otlar, virüslerin kültür bitkileri dışında çoğalması ve barınması için alternatif konukçulardır. Tarım alanlarında iyi bir yabancı ot kontrolü virüs hastalıkları ile mücadele için önemlidir. Tütün mozayik virüsü, Domates mozayik virüs gibi temas ile çok kısa sürede bulaşan virüslerin yayılmasını önlemek için bazı önlemler alınabilir. Kültürel işlemler sırasında (örneğin Sırık Domatesin bağlanması gibi) ellerin her sıra başında sabunlu suyla yıkanması bulaşmayı azaltmada etkili olur. Veya ellerin arada sırada sulandırılmış süte Batırılması bitkilerin araziye aktarılması sırasında temas ile bulaşmaları azaltabilir. Tarım aletlerin %10’luk sulandırılmış çamaşır suyu ile dezenfekte edilmesi önerilebilir. Çalışılırken sigara içilmemesi önemlidir. Çünkü Tütün mozayik virüsü (TMV) kuru sigara Tütününde uzun süre kalıcıdır. Kolay kolay hastalık oluşturma özelliğini dış ortamda dahi yitirmez. Başlangıçta fark edilirse bulaşık bitkilerin imha edilmesi daha sonraki yayılmayı azaltmaya katkıda bulunur.

• Bitki Bakteriyel Hastalıkları İle Mücadele • Bakteriyel hastalıklar ile mücadele genellikle koruyucu önlemelere dayanır. Tedavi edici yöntemler sınırlıdır. • 1. Sağlıklı üretim materyali kullanılması • 2. Bir önceki yıldan kalan bitki artıklarının sökülüp yakılması (Sanitasyon Tedbiri) • 3. Mevcut üretim sezonunda hastalık beliritilerinin görüldüğü bitkilerin sökülüp imha edilmesi (Eradikasyon) • 4. Hasta bitkilere temastan sonra ellerin ve tarım aletlerinin dezenfeksiyonu (Sanitasyon) • 5. Ekim Nöbeti • 6. Varsa dayanıklı çeşitlerin kullanımı • 7. Bordo bulamacı, bakır oksit gibi bakırlı bileşiklerin kullanımı • 8. Tohumla taşınan bakteriler için tohumların % 10 -20’lik sodyum hidroklorit (Çamaşır suyu) ile muamele edilmesi. • 9. Antibiyotik Uygulaması (Streptomisin, oxytetrasiklin gibi)…. Ekonomik Değil.
- Slides: 149